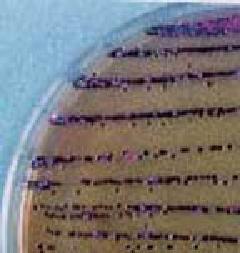
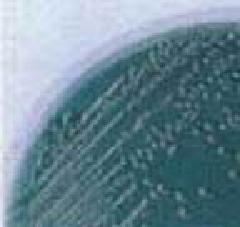

ここから本文です。
食中毒菌検査
最終更新日 2024年4月2日
食中毒とは
食中毒とは「食品や添加物、容器包装などに含まれたり、付着した微生物、化学物質、自然毒などを摂取することによって起きる衛生上の危害」のことです。
食中毒発生件数は年によって変動がありますが、平成20年以降は毎年件数としておよそ年間1,000件程度、患者数としては20,000人前後発生しています。そして、その病因物質の80%以上は細菌やウイルスによるものです。
ここでは細菌が原因となる食中毒をいくつかご紹介します。
細菌性食中毒は、
感染型食中毒
付着した細菌そのものによって起こる食中毒です。
サルモネラ
DHL寒天培地上のサルモネラ
サルモネラはすべてのほ乳類、鳥類、は虫類、両生類に広く分布し、おそらくそれらからの汚染によって土壌、河川水など自然環境から分離されることもまれではありません。また、乾燥によく抵抗し、土壌や冷凍食品中でも数年間生存します。原因食品は主に卵や食肉です。
検査法
活性の低い菌の活性を高めるためBPWを用い前増菌し、その後RV培地及びTT培地などで増菌し、DHL寒天培地またはクロモアガーサルモネラ培地等で分離し、性状試験により確定します。
腸炎ビブリオ
TCBS寒天培地上の腸炎ビブリオ
この菌は海水や海の泥の中に常在しているため、約3~7%の塩分濃度の環境下では生育に適していますが真水には弱く、水道水では生育できません。また熱にも弱く60℃、10分ほどの加熱で死滅してしまいます。
海水温の上昇に伴って腸炎ビブリオが増殖し始めるため食中毒の流行は夏場となりますが、輸入食材が増えていることから一年を通して食中毒の発生の可能性があります。
主たる原因食品は海産魚介類などですが、まな板・ふきん・手指などを介した二次汚染食品が原因となった食中毒事例も多くあります。野菜の浅漬けなどが二次汚染されると適度な塩分で菌が増殖し、食中毒を起こします。
予防法は、魚介類を調理前に水道水でよく洗うことや、まな板を魚専用に区別することが有効です。また、保存は10℃以下にし、生ものは早めに食べるようにしましょう。
検査法
MPN法や定性試験があります。アルカリペプトン水で増菌し、クロモアガービブリオまたはTCBS寒天培地で分離し、性状試験を行い確定します。
カンピロバクター
家畜、家禽、ペットなどあらゆる動物の腸管内に生息しています。そのため食肉やその加工品が原因となることが多く、野生動物や家畜のし尿で汚染された水からも感染します。低温でも長期間生存し、他の菌とは異なり少量でも食中毒を起こします。近年では鶏刺しや加熱不十分な焼き鳥などを原因食品として多くの食中毒が発生しています。
食肉は清潔に取り扱い、中心部を75℃で1分以上、十分に加熱してから食べましょう。
エロモナス
淡水中(0~3%の塩分濃度)に多くが生息し、魚類が感染すると大量死滅します。ヒトには下痢原因菌として、また、脂肪・筋肉組織や臓器への感染菌として認識されています。
感染源は水系(河川水、沿岸海水、泥や土)によるもので、自然環境に広く分布し、食品では魚介類、野菜等など広範囲に検出されています。
プレシオモナス・シゲロイデス
淡水系に生息し、河川、池、湖などの水や泥土中に広く存在しており、夏期の水温上昇時には水からよく検出されるようになります。我が国の集団発生事例は少なく、水や魚介類の加熱不十分が主な原因でした。
ナグビブリオ
この菌は、海水と淡水が混ざり合う河口付近などの汽水域に生息しており、100万個以上の菌を経口的に摂取することで6~72時間の潜伏期間を経た後、水様性下痢・嘔吐・腹痛・発熱などの急性胃腸炎症状を呈します。コレラ状の症状を呈する場合もあります。
ビブリオ・ミミカス
ナグビブリオと性状が極めて似ており、塩分濃度が6%以下で増殖できるため、淡水や海水に分布しています。この菌による症状もナグビブリオと似ています。
ビブリオ・フルビアリス
沿岸海域および汽水域の海水及びそこに生息する魚介類などからしばしば分離されます。生態は腸炎ビブリオと同様ですので、その原因食品および感染経路も同様と考えられます。
このページへのお問合せ
医療局健康安全部中央卸売市場本場食品衛生検査所
電話:045-441-1153
電話:045-441-1153
ファクス:045-441-8009
メールアドレス:ir-honjo@city.yokohama.lg.jp
ページID:224-824-110







